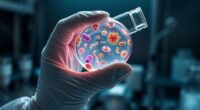
reviving microbiomes for health

Olfactory diagnostics help you detect nasal or neurological issues early, often before symptoms appear. Tests like odor identification, thresholds, or brain imaging reveal changes in smell function that signal potential problems, such as neurodegenerative diseases or nasal obstructions. By understanding these assessments, you can identify risks sooner and take preventive action. If you’re curious about how smell tests can reveal hidden health concerns, exploring further will uncover more insights.
Key Takeaways
- Psychophysical odor tests can detect subtle olfactory deficits before clinical symptoms emerge.
- Structural MRI may reveal early brain changes associated with neurodegenerative diseases affecting smell.
- Olfactory event-related potentials (OERP) can identify neural response abnormalities prior to symptomatic decline.
- Nasal examinations can uncover preclinical nasal obstructions or mucosal changes linked to future smell loss.
- Monitoring olfactory function over time helps identify early disease markers before noticeable symptoms appear.

Have you ever wondered how clinicians identify and evaluate problems with your sense of smell? It’s a complex process that combines various diagnostic methods to determine the cause and severity of olfactory dysfunction. The main clinical tool is psychophysical testing, which involves validated odor identification and threshold tests like the CCCRB, UPSIT, or Sniffin’ Sticks. These tests are simple for you to perform and provide reliable measures of your olfactory capabilities. They help distinguish between partial loss, such as hyposmia, and complete loss, like anosmia.
Clinicians use simple, reliable smell tests like UPSIT and Sniffin’ Sticks to assess olfactory function.
In some cases, clinicians turn to electrophysiological assessments to get an objective view of your olfactory system. Olfactory event-related potentials (OERP), recorded via EEG, can measure brain responses to odors. While these tests offer valuable data, they are technically complex and not widely available. Structural imaging techniques, like MRI, allow doctors to visualize your brain’s olfactory-related areas, such as the olfactory bulb and orbitofrontal cortex. They can reveal volume loss or tumors that might be causing your smell issues. Though functional MRI (fMRI) can analyze how your brain processes odors, its use for individual diagnosis remains limited due to interpretation challenges.
Sometimes, your doctor might need to perform nasal endoscopy or mucosal biopsy to look directly at your nasal cavity and olfactory epithelium. These procedures help identify local causes like tumors, inflammation, or infections that could obstruct or damage your olfactory pathways. The combination of these approaches helps clinicians pinpoint whether your smell loss is temporary, reversible, or permanent.
Understanding the terminology is also essential. Complete loss of smell, anosmia, can affect one or both nostrils, while hyposmia refers to a reduced sense of smell. Dysosmia involves altered or distorted perception of odors, and phantosmia is experiencing smells that aren’t actually present. Sometimes, people have olfactory agnosia, where the sense of smell is intact but they can’t recognize specific odors. Recognizing these distinctions guides treatment and prognosis.
Diagnosing the cause of smell loss can alert clinicians to underlying health issues. For example, traumatic brain injury often damages the olfactory bulb or tract, leading to anosmia. Neurodegenerative diseases like Parkinson’s and Alzheimer’s frequently involve early olfactory impairment, making smell tests useful for early detection. Infections, nasal diseases, and exposure to toxins or nutritional deficiencies can also disrupt your olfactory function. Recent advances in molecular imaging have further enhanced the ability to detect subtle changes in olfactory pathways.
Through a combination of psychophysical testing, electrophysiology, imaging, and nasal examinations, clinicians can assess your olfactory health accurately. These methods not only help identify causes but also support early diagnosis of diseases, monitor progression, and guide treatment strategies. They enable you to understand your condition better and provide insight into your overall neurological health before more obvious symptoms appear.

MOXĒ Smell Training Kit, Made in USA, 8 Essential Oils, Olfactory Regeneration, Helps Restore Sense of Smell, Natural Therapy for Smell Loss (Phase 1 & Phase 2 Bundle)
Made in the USA. This smell therapy bundle includes eight essential oil nasal inhalers that help restore and…
As an affiliate, we earn on qualifying purchases.
As an affiliate, we earn on qualifying purchases.
Frequently Asked Questions
Can Olfactory Diagnostics Detect All Types of Diseases?
You wonder if olfactory diagnostics can detect all diseases. The truth is, it can’t. While it’s effective for neurodegenerative conditions like Alzheimer’s and Parkinson’s, not all diseases produce distinctive or detectable odors. Factors like environmental odors, individual differences, and disease stages can limit accuracy. So, while promising, olfactory diagnostics aren’t yet capable of universally detecting every disease, but ongoing research aims to expand their scope.
How Early Can Smell Changes Indicate Illness?
You want to know how early smell changes can signal illness. Research shows that smell loss can appear years before symptoms in diseases like Parkinson’s and Alzheimer’s. For Parkinson’s, it may happen up to four years in advance, and for Alzheimer’s, it can be detected even earlier. COVID-19-related smell loss often occurs within days of infection. So, your sense of smell can serve as a vital early warning, sometimes years ahead of other symptoms.
Are Olfactory Tests Suitable for Children?
Like a key opening a hidden door, olfactory tests open new pathways for detecting health issues early. You’re better off with these tests because they’re tailored for children, using age-appropriate odors and simple picture recognition. They work well even for young kids, helping you catch problems before symptoms appear. As children grow, their accuracy improves, making these tests a valuable tool in pediatric health screening and early diagnosis.
What Factors Can Impair Olfactory Diagnostic Accuracy?
You should know that various factors can impair olfactory diagnostic accuracy. Aging naturally reduces smell function, while health conditions like neurodegenerative diseases, diabetes, and hypertension lower detection reliability. Environmental exposures, lifestyle choices such as smoking or alcohol use, and psychological factors like depression can also affect results. Additionally, self-reporting often underestimates dysfunction, making objective testing and measurements like MRI essential for accurate diagnosis.
Is Olfactory Testing a Replacement for Traditional Diagnostic Methods?
While olfactory testing offers a gentle nudge in early detection, it’s not quite ready to replace traditional diagnostics. You should see it as a helpful supplement, providing quick, non-invasive insights alongside more precise methods like PCR or imaging. Its strengths lie in screening and early warning, but it’s best used in combination with established tests to guarantee accurate, thorough diagnosis, rather than as a standalone solution.

Olfactory Scent Test Kit Non Diagnostic
Used for: Earliest, Unnoticed Symptoms caused by: Viruses, Alzheimer's Disease, Parkinson's, Disease Neurological Disorders, Concussion
As an affiliate, we earn on qualifying purchases.
As an affiliate, we earn on qualifying purchases.
Conclusion
So, next time you’re told to trust your nose, remember it might just be the best doctor you never knew you had. While sniffing out diseases before symptoms appear sounds like magic, it’s really just science in disguise—waiting for you to notice that odd smell. Ironically, your nose might save you from illness, but only if you’re paying attention. Who knew that a simple sniff could be the key to early detection?

Nasal Syringe for Baby – 4PCS – Safe Silicon Baby Nasal Aspirator Qucik Syringe Nose Cleaner Rinsing Tool for Baby/Infant/Kid
Effective Nose Clean – Our nasal irrigator help children breathe better by cleaning children's nasal cavities,and soften flush…
As an affiliate, we earn on qualifying purchases.
As an affiliate, we earn on qualifying purchases.
olfactory function assessment tools
As an affiliate, we earn on qualifying purchases.
As an affiliate, we earn on qualifying purchases.